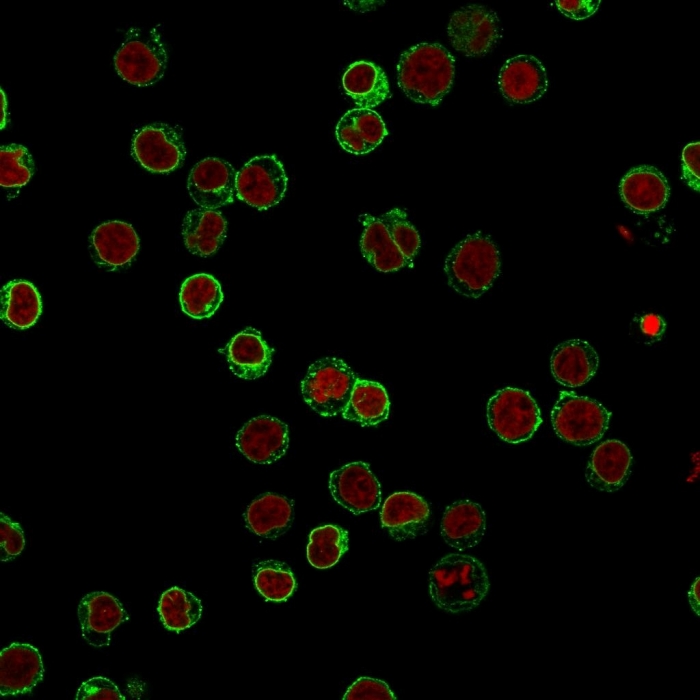

Flow Cytometric Analysis of Jurkat cells. CD3e Mouse Monoclonal Antibody (B-B12) followed by Goat anti-Mouse IgG-CF488 (Blue); Isotype Control (Red).
Immunofluorescence Analysis of Jurkat cells labeling CD3e with CD3e Mouse Monoclonal Antibody (B-B12) followed by Goat anti-Mouse IgG-CF488 (Green). The nuclear counterstain is Reddot (Red).
Recognizes the epsilon-chain of CD3, which consists of five different polypeptide chains (designated as gamma, delta, epsilon, zeta, and eta) with MW ranging from 16-28kDa. CD3 is expressed, typically at high levels, on peripheral T cells and majority of T cell neoplasms. Thymocytes express CD3 at different level on the cell surface in the course of differentiation and, in cortical thymus, CD3 is predominantly Intracytoplasmic. The CD3 complex is closely associated at the lymphocyte cell surface with T cell antigen receptor (TCR) and is involved in transducing antigen-recognition signals into cytoplasm of T cells and in regulating the cell surface expression of the TCR complex.
There are no reviews yet.